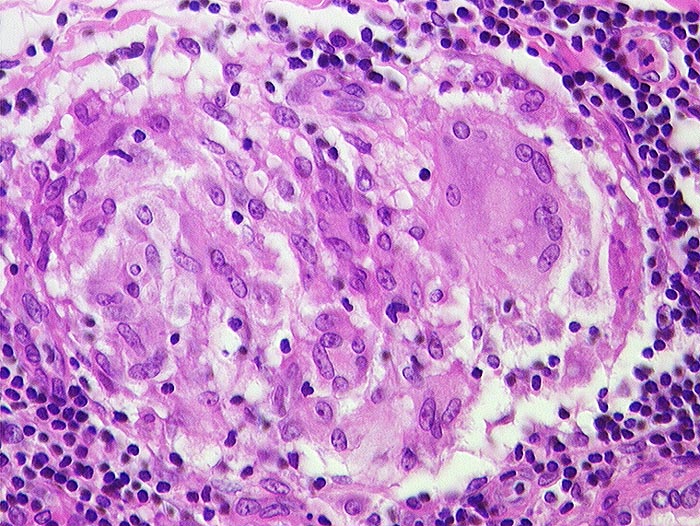

PathoPic – image database / PathoPic ID 706 - Sarkoidosegranulom
de
Diagnose
Sarkoidosegranulom
Diagnose Gruppe
Entzündung / Reparatur
Topographie
Lymphknoten, Lunge
Topographie Gruppe
Lymphatische Gewebe, KM, Milz
Beschreibung
Granulom aus Epitheloidzellen und einer Riesenzelle ohne Nekrosen.
Zusatzbefund
Granulome in Lungen, Bronchialschleimhaut, Leber, Milz und Lymphknoten pulmonal
Bilder Typ
Histologie
Alter
56
Geschlecht
unbekannt
Datum
Ersteintrag: 16.11.2001